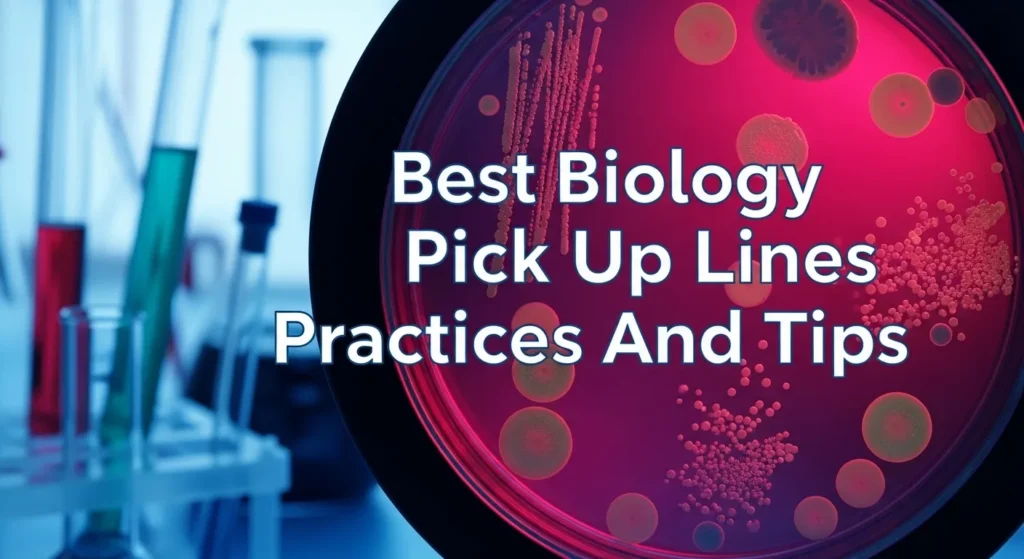
Best Biology Pick Up Lines Practices And Tips

I recently experienced something interesting related to biology pick up lines. I was chatting with a friend when this term suddenly came up, and honestly, I had no idea what it meant at first.
It caught me off guard, and I started thinking, “Wait… am I missing something here?”
I didn’t want to respond awkwardly or misunderstand the conversation, so instead of guessing, I decided to look into the meaning of biology pick up lines.
At first, it seemed a bit confusing, but once I explored it, everything started to make sense.
I realized that these lines are usually clever, funny, and sometimes a bit nerdy ways of flirting using biology related terms.
Understanding this not only cleared my confusion but also made me appreciate the humor behind them.
After learning the proper context, I was able to respond confidently without feeling unsure or out of place. Now, whenever I come across biology pick up lines in chats or on social media
Best Biology Pick Up Lines Practices And Tips
Before jumping into examples, here’s how to deliver biology pick up lines like a pro:
- Say it with confidence, not hesitation
- Smile or add a playful tone
- Match the vibe of the conversation
- Use them as icebreakers, not full conversations
- Avoid overusing lines keep it natural
- Be ready to follow up with genuine talk
- Keep it light and fun, not forced
- Adjust based on the person’s interest in science
- Timing matters don’t interrupt serious moments
- Practice delivery casually with friends
- Use eye contact when possible
- Keep it short and snappy
- Don’t explain the joke unless needed
- Read their reaction and adapt
- Confidence beats perfection every time
Funny Biology Pick Up Lines Examples

These are perfect for laughs and breaking the ice:
- Are you a mitochondrion because you are the powerhouse of my heart
- Are you DNA helicase because you just unzipped my genes
- I must be a neuron because I am firing for you
- Are you made of glucose because you are sweet energy
- You must be oxygen because I cannot live without you
- Are you a cell membrane because you control what comes into my heart
- I feel like ATP because I am full of energy when I see you
- Are you evolution because you just changed my life
- My love for you is like cell division it just keeps growing
- Are you a ribosome because you make my heart proteins
- You must be a virus because you have infected my mind
- Are you a chromosome because you complete me
- I must be photosynthesis because you light up my world
- Are you RNA because you translate my feelings
- Are you biology homework because I cannot stop thinking about you
Advanced And Smooth Biology Pick Up Lines Strategies
For when you want to sound confident and impressive:
- Are you my DNA because I feel a strong connection deep inside
- I think we have great chemistry, but biology confirms it
- You must be natural selection because you are the best choice
- My heart beats faster like a stimulated neuron when I see you
- Are you an enzyme because you speed up my feelings
- I feel like we have perfect genetic compatibility
- You and I must share a strong evolutionary bond
- I am drawn to you like cells to oxygen
- You activate something in me like a catalyst
- Being with you feels like homeostasis perfect balance
- Are you my nervous system because you control my emotions
- You must be adaptation because you fit perfectly in my life
- I feel like we are two strands of DNA better together
- You trigger dopamine levels I cannot ignore
- Our connection feels scientifically undeniable
Clever And Unique Biology Pick Up Lines Ideas
Stand out with these creative lines:
- Are you CRISPR because you just edited my heart
- I must be a stem cell because I can become anything for you
- Are you a genome because you contain everything I need
- My love for you is like evolution it only gets stronger
- Are you biodiversity because you make life interesting
- I feel like a microscope because I cannot stop focusing on you
- Are you an ecosystem because you complete my world
- You must be a mutation because you are rare and beautiful
- Are you genetics because you run through my mind
- I think we have a dominant connection
- Are you a cell cycle because you keep repeating in my thoughts
- You are like DNA unique and irreplaceable
- Are you bioelectric because you spark something in me
- You must be a protein because you build me up
- I feel like science proved something when I met you
Cute And Charming Biology Pick Up Lines
Sweet and endearing options:
- Are you my heartbeat because you keep me alive
- You must be sunshine because you help me grow
- I think my heart evolved just for you
- You make my world feel like a perfect ecosystem
- Are you oxygen because I need you every second
- I feel complete like a perfect cell when I am with you
- You are the reason my heart stays in rhythm
- Are you photosynthesis because you bring me life
- I think you are my natural habitat
- Being with you feels like perfect balance
- You make my heart bloom like a flower
- I feel safe with you like cells in homeostasis
- You are the missing piece in my biology
- I think my DNA chose you
- You make everything feel alive
Cheesy And Playful Biology Pick Up Lines
Sometimes cheesy is the best way to go:
- Are you made of cells because you have me divided
- You must be DNA because you got me twisted
- Are you ATP because you give me energy
- I must be a lab experiment because I react to you
- Are you a petri dish because I want to grow with you
- You must be biology class because I am interested
- Are you a microscope because you magnify my feelings
- I think you mutated my heart
- Are you a lab coat because you cover my thoughts
- You must be a gene because you express beauty
- I feel like a test subject around you
- Are you an organism because you complete life
- You must be science because I cannot ignore you
- I feel like a specimen when you look at me
- You are the highlight of my experiment
Flirty And Engaging Biology Pick Up Lines
These lines invite conversation:
- Are you DNA because I want to learn everything about you
- What is your favorite cell type because mine is you
- Do you believe in evolution or did we just evolve together
- Are you a neuron because I cannot stop thinking about you
- What is your favorite biology topic because I would love to discuss it
- Are you oxygen because you take my breath away
- Do you study biology or are you naturally this amazing
- Are you a chromosome because I feel connected
- What is your favorite ecosystem because I would choose yours
- Are you ATP because you keep me going
- Do you believe in chemistry or should we test biology
- Are you a protein because you build attraction
- What is your genetic secret for being this attractive
- Are you a catalyst because you started something
- Can I be your lab partner
Bold And Confident Biology Pick Up Lines
For those who like taking risks:
- I do not need a lab to prove we have chemistry
- I am confident we are genetically compatible
- You are exactly my type biologically and emotionally
- I am not guessing there is real attraction here
- You and I would make perfect sense scientifically
- I think we are meant to connect
- I do not need evidence to know I like you
- This feels like more than coincidence
- I know what I want and it is you
- I am ready to explore this connection
- We have undeniable energy
- I am not here to experiment I am serious
- You stand out like a rare mutation
- I trust my instincts about you
- This connection feels real
Short Biology Pick Up Lines
- You are my DNA
- You complete my cells
- You are pure energy
- I choose you naturally
- You make life better
- You are my oxygen
- My heart reacts to you
- You are my biology
- I feel alive with you
- You are my favorite subject
- You are my type
- You spark something
- You feel right
- You are unique
- I am drawn to you
Nerdy Biology Pick Up Lines
Perfect for science lovers:
- Are you a eukaryotic cell because you have complexity
- I must be RNA polymerase because I am transcribing feelings
- Are you the Golgi apparatus because you package perfection
- I feel like mitosis because I want to multiply moments with you
- Are you homeostasis because you keep me balanced
- You must be a ligand because you bind to my heart
- Are you osmosis because you move into my thoughts
- I feel like a synapse when I am close to you
- Are you an allele because you are dominant
- You must be phylogeny because you define connections
- Are you a hormone because you affect everything
- I feel like biology proved love exists
- Are you biodiversity because you fascinate me
- You must be a receptor because you understand me
- Are you adaptation because you fit perfectly
Biology Pick Up Lines for Texting
- I just learned about DNA and thought of you
- You must be oxygen because I cannot stop thinking about you
- I think we have scientific chemistry
- Are you ATP because you give me energy all day
- Random question but are you into biology or just naturally amazing
- You crossed my mind like a neuron signal
- I think my heart reacted to your message
- You are my favorite notification
- I feel a connection even through text
- You make my day better instantly
- I think we should test this chemistry in real life
- You got me smiling like a science nerd
- I cannot explain it but you stand out
- I like talking to you more than I expected
- You are different in a good way
Dirty Biology Pick Up Lines
Keep it respectful and playful:
- Are you a cell membrane because I want to get closer
- I feel like DNA because I want to intertwine
- Are you a nucleus because you control everything
- I must be an enzyme because I react strongly
- Are you biology because you excite me
- I feel a strong attraction here
- You trigger something deeper
- Are you a hormone because you influence me
- I cannot ignore this connection
- You bring out a different side of me
- I feel energy when I am near you
- This feels intense in a good way
- You make my heart race
- I am drawn to you naturally
- There is chemistry here
Common Mistakes to Avoid with Biology Pick Up Lines
Avoid these errors:
- Using overly complicated scientific terms
- Sounding robotic or rehearsed
- Ignoring the other person’s reaction
- Using lines at inappropriate times
- Overusing too many lines in a row
- Being too serious about it
- Forcing humor that does not land
- Not adapting to the situation
- Being disrespectful or offensive
- Explaining the joke too much
- Lack of confidence in delivery
- Using outdated or cringe lines
- Not following up with real conversation
- Ignoring boundaries
- Trying too hard to impress
How to Use Biology Pick Up Lines Effectively
- Start light and playful
- Use one line, then transition to real talk
- Read body language or responses
- Keep things natural and spontaneous
- Use humor as a bridge, not a crutch
- Be authentic your personality matters most
- Adapt based on the situation
- Practice makes delivery smoother
- Stay respectful at all times
- Confidence is key
Digital vs Real-Life Pickup Lines
Online (Texting):
- Easier to be creative
- Less pressure
- Time to think before sending
- Can use emojis and tone
Real Life:
- More impactful
- Body language matters
- Requires confidence
- Creates instant connection
FAQs:
Does biology pick up lines actually work?
Yes, they work when used with confidence and humor. They are great conversation starters but should be followed by genuine interaction.
When is the best time to use a pickup line?
At the beginning of a conversation or when the mood is light and playful.
Are biology pick up lines only for science lovers?
No, anyone can enjoy them. Even people unfamiliar with biology often find them funny and creative.
Conclusion:
Biology pick up lines bring science and humor together in a fun, modern way. They make conversations more engaging, especially for students and science lovers who enjoy clever wordplay.
If you want to impress someone or simply break the ice, these lines can add personality and creativity to your approach.
Keep it light, confident, and genuine because the best connections, just like in biology, grow naturally with the right environment and a little spark of chemistry.

Archer Hayes creates engaging, fast-paced novels with a mix of action, intrigue, and emotion. His characters are relatable, and his stories resonate with a wide audience. Fans love the depth and creativity he brings to every plot. Find out more about his books on pikyupline.com.


